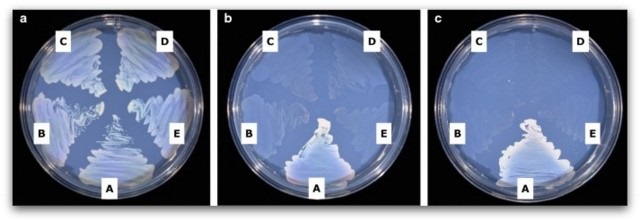
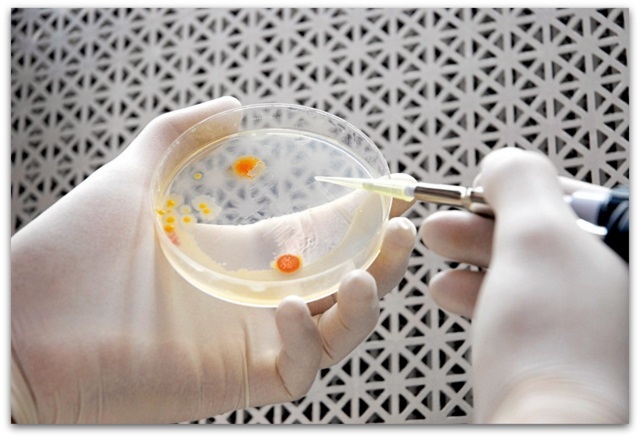

Јужнокорејски научници смислиле систем кој користи добро позната бактерија за фаќање на CO2 од воздухот и за производство на разградлива биопластика.
Тим хемиски инженери од Јужна Кореја смислиле прототип на систем со кој добро позната бактерија би можела да го претвори јаглерод диоксидот од воздухот во корисна биопластика. Тоа би било многу елегантно решение за два глобални проблеми во еден потег.
Неодамна, микроскопското решение за растечкиот проблем со пластиката во светот привлече големо внимание, во форма на бактерии кои грицкаат пластика и се способни да го разградат пластичниот отпад за неколку часа. Изнаоѓањето нови начини за производство на пластика од други извори освен фосилните горива и нивните деривати е исто така клучно за намалување на зависноста на човештвото од фосилните горива.
По многу обиди досега, смислен е нов систем
Досега, многу хемиски инженери дошле до идеја дека зголемувањето на нивото на јаглерод диоксид во атмосферата на Земјата би можело да биде неискористен ресурс за производство на пластика или други производи базирани на јаглерод, како млазно гориво или бетон, само ако можеме да го заробиме CO2 од воздухот и да се направи нешто од тоа.
Еден начин да се претвори гасот CO2 во други корисни соединенија што содржат јаглерод е да се користи електрична енергија во реакција наречена електролиза. Но, тој метод, иако ветувачки, најчесто произведува почетни соединенија со краток ланец од само еден до три јаглеродни атоми. Сепак, создавањето на хемикалии со подолг јаглероден синџир од CO2 е многу потешко.
Во овој поглед, гореспоменатиот тим хемиски инженери од Корејскиот напреден институт за наука и технологија (KAIST) разви систем од два дела за трансформирање на CO2 во вообичаен тип на биопластика со помош на бактериски вид наречен Cupriavidus necatorr.
Како функционира новиот систем?
Првиот чекор на системот е електролизатор кој го претвора гасниот CO2 во формат, кој потоа се става во резервоар за ферментација, каде што бактериите почнуваат да го вршат својот дел. C. necator е добро познат по својата способност да синтетизира јаглеродни соединенија, како што се поли-3-хидроксибутират или PHB, вид на биоразградлив и компостлив полиестер, од други извори на јаглерод. Во гореспоменатиот систем на корејски инженери, C. necator ја внесува суровината од реакцијата на електролиза и акумулира гранули од PHB, кои потоа може да се извлечат од акумулираните ќелии.
Истиот раствор циркулира помеѓу реакцијата на електролиза и резервоарот за ферментација, со мембрана што ги одвојува двете комори така што бактериите се изолирани од нуспроизводите на реакцијата на електролиза. Ако системот се напојува со обновлива енергија, тогаш тоа би можело да биде начин без фосилни горива за производство на биопластика која истовремено користи CO2, кој човештвото всушност треба брзо да го отстрани од воздухот, со цел да го ограничи глобалното затоплување.
Применливо и на индустриско ниво?
Авторите на студијата, која е објавена во списанието PNAS, се оптимисти дека нивниот пристап е скалабилен и донекаде може да помогне да се трансформира начинот на кој се произведува пластиката.
„Резултатите од ова истражување се технологии кои можат да се применат за производство на различни хемиски супстанци како и биопластика и се очекува да се користат како клучни делови потребни за да се постигне јаглеродна неутралност во иднина“, посочуваат тие.
Лабораториските експерименти покажале дека клетките C. necator во хибридниот систем можат да синтетизираат толку многу PHB, што по 120 часа или 5 дена од работењето, полиестерскиот производ претставува до 83 проценти од тежината на сувата клетка на бактеријата. Врз основа на овие резултати, корејските научници тврдат дека нивниот систем е 20 пати попродукти
Тие исто така забележуваат дека нивниот систем може да работи без прекин, се додека бактериските клетки се надополнуваат секој ден и се отстранува пластичниот производ за да се одржат реакциите. Тоа континуирано производство би било од суштинско значење за системот да функционира на индустриско ниво. Досега, истражувачите го тестирале само 18 дена и произвеле 1,45 грама полиестер.